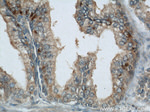
GSK3B Antibody in Immunohistochemistry (Paraffin) (IHC (P))

Search
Proteintech
GSK3B Polyclonal Antibody
{{$productOrderCtrl.translations['antibody.pdp.commerceCard.promotion.promotions']}}
{{$productOrderCtrl.translations['antibody.pdp.commerceCard.promotion.viewpromo']}}
{{$productOrderCtrl.translations['antibody.pdp.commerceCard.promotion.promocode']}}: {{promo.promoCode}} {{promo.promoTitle}} {{promo.promoDescription}}. {{$productOrderCtrl.translations['antibody.pdp.commerceCard.promotion.learnmore']}}
产品信息
22104-1-AP
种属反应
已发表种属
宿主/亚型
分类
类型
抗原
偶联物
形式
浓度
规格
纯化类型
保存液
内含物
保存条件
运输条件
产品详细信息
This antibody recognize the C-terminal of GSK3B.
Immunogen sequence: ELRDPNVKL PNGRDTPALF NFTTQELSSN PPLATILIPP HARIQAAAST PTNATAASDA NTGDRGQTNN AASASASNST (355-433 aa encoded by BC000251)
靶标信息
GSK3B is a proline-directed serine/threonine protein kinase involved in energy metabolism, neuronal cell development and body pattern formation. It is a negative regulator of glucose homeostasis and is involved in energy metabolism, inflammation, ER-stress, mitochondrial dysfunction, and apoptotic pathways. GSK3B is a critical component of the Wnt/beta-catenin signaling pathway, and its activity results in the inhibition of Wnt signaling by mediating the degradation of beta-catenin. GSK3B is also involved in the Hedgehog, Notch, and insulin signaling pathways.
仅用于科研。不用于诊断过程。未经明确授权不得转售。
生物信息学
蛋白别名: EC 2.7.11.26; FA; Factor A; Glycogen synthase kinase-3 beta; GSK 3 beta; GSK 3B; GSK-3 beta; GSK-3 beta GSK3B; GSK-3b; GSK3 beta; GSK3B; kinase; pp37; Serine/threonine-protein kinase GSK3B; unnamed protein product
基因别名: 7330414F15Rik; 8430431H08Rik; C86142; GSK-3; GSK-3beta; GSK3; GSK3B
UniProt ID: (Human) P49841, (Mouse) Q9WV60, (Rat) P18266
Entrez Gene ID: (Human) 2932, (Mouse) 56637, (Rat) 84027